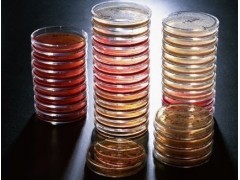

产品名称:
MR-VP培养基
产品用途及说明:用于大肠杆菌的甲基红和VP试验(SN标准)
包 装 :250
培养基 - 成分
培养基的成分包括:碳源、氮源、矿物质,以及其他必需物质。这些成分通过生物反应过程,生成生物物质、生物化工产品,并放出CO2、H2O和热量。 培养基的成分还可以由发酵过程中所需的元素出发,如C、H、O、N、S、P、Mg、K等。此外,必要时还有一些需要量很少的微量元素,如Fe、Zn、Cu、Mn、Co、Mo、B等。在发酵过程中某些生物本身不能合成的物质,如氨基酸、维生素或核苷酸等,必要时亦作为营养物质加入到培养基中。
碳源
具有双重作用。生物在产生生物物质或生物化工产品过程中,它不仅为其提供碳源,也为其提供能源。碳水化合物是微生物发酵中的主要碳源,包括淀粉、葡萄糖、蔗糖和乳糖等。此外,植物油如豆油、棉籽油、玉米油等亦常被应用作为碳源。这类油常与表面活性剂合用,以消除发酵过程中所产生的泡沫。甲醇可用以生产单细胞蛋白。正烷烃类可用以生产有机酸、氨基酸和维生素等,甚至二氧化碳也可作为光合细菌的碳源。
氮源
包括无机氮源和有机氮源。无机氮源包括氨、铵盐及硝酸盐等,它们在被应用时应注意发酵中pH的变化;有机氮源包括氨基酸、蛋白质及尿素等,有机氮源的加入往往加快了生物的生长。因考虑到成本因素,一些有机氮源,如黄豆饼粉、花生饼粉、棉籽饼粉、玉米浆、鱼粉、酵母粉等常被选用。
培养基的组成中除了水分外,碳源和氮源的含量是zui大的。碳源含量一般不超过10%,氮源含量较低,一般碳氮比应为3~4:1。碳、氮源含量不能过高的原因是避免产生基质或产物对反应的抑制和因渗透压过高引起细胞失水而死亡。
矿物质
培养基中 Mg、P、K、S、Ca、Cl常是主要的矿物质的组成成分,其他如Co、Cu、Fe、Mn、Mo及Zn也往往不可少,但需要量很小,可从其他主要培养基成分中得到。如是使用合成培养基就需要把这些微量元素加进去。它们不仅为生物生长所必需,也是为了得到某些产物所必不可少者。例如生物合成青霉素或头孢菌素需要一定量的硫;生物合成维生素B12需要一定量的钴。
维生素
某些生物在培养过程中需要某些维生素,往往在天然培养基中已经提供了必要的维生素,但在某些特殊情况下需单独加入维生素。例如在谷氨酸生产过程中需加入生物素,某些植物细胞培养中需要硫胺素(维生素B1)。
缓冲剂
由于发酵过程中pH对形成生物产物的影响很大,为维持稳定的pH,常采用缓冲剂,例如碳酸钙或磷酸盐。后者除能调节pH外,还为培养基提供磷源。 前体或代谢调节剂 前体是指某一种化合物被加入到发酵培养基中之后,能直接参与产物的生物合成中去。如在青霉素G(即苄基青霉素)的发酵过程中,加入适当的苄基化合物(如苯乙酸)能明显提高青霉素 G的产量。 代谢调节剂中包括抑制剂和诱导剂,当一种抑制剂加入到发酵过程中时能抑制不需要的产物,而大量产生所需的特定产物(或中间体)。如在四环素发酵中,加入溴化物能抑制金霉素(即氯四环素)的形成,从而增加四环素的产量。至于诱导剂,多数酶的生成需要它来诱导。在正常情况下,酶所需的基质或基质的类似物,可用作诱导剂。如曲霉产生α-淀粉酶时需要淀粉作诱导剂。
防沫剂
也称消泡剂,一种表面活性剂,能降低泡沫的表面张力,从而消除发酵中泡沫。在多数好气发酵中需解决泡沫问题。泡沫形成的主要原因是由于在培养基中有蛋白质,从而在发酵液和空气泡之间的界面上形成膜,这种膜不易被破坏。泡沫大量形成后,能进入发酵罐的排气管道而造成发酵染菌及发酵液流失。常用的消泡剂为油脂类、酯类、硅油及聚氧乙烯-聚氧丙烯甘油醚。加入消泡剂能降低氧传递率达50%,因此消泡剂应尽量少加。
在大规模连续发酵培养单细胞蛋白中,需将发酵液循环以充分利用其中的营养物质。但在循环过程中需调节其中营养物的含量水平。采用此工艺时,常注意防止在单细胞蛋白饲料中,过多积累不必要的其他代谢物。 动物细胞的培养基,包括葡萄糖(有时加半乳糖)、氨基酸(有时加蛋白水解液)、维生素、激素、无机盐及血清等,其中血清常是必要的,且含量要占5%~10%。由于它的来源有限,价格高昂,因此正在进行无血清培养的研究。植物细胞的培养基,除了包括微生物培养基的基本成分外,还必须包含植物激素(如生长素、细胞分裂素等)、植物生长调节剂(人工合成的外源激素)及必要的前体。
标准品对照品,抗体,生化试剂,Elisa试剂盒,血清,USP级试剂,美国药典级试剂,就在上海劲马生物,欢迎您来电来函。
“
MR-VP培养基”本公司信誉一、质量一、品牌一,打造优良的服务,专业供应分子生物学试剂盒,ELISA试剂盒,生物试剂,标准品,”相关信息欢迎来电咨询!
本页产品地址:http://www.geilan.com/sell/show-2123825.html

![]()
 免责声明:以上所展示的[ MR-VP培养基]信息由会员[上海仁捷生物科技有限公司]自行提供,内容的真实性、准确性和合法性由发布会员负责。
免责声明:以上所展示的[ MR-VP培养基]信息由会员[上海仁捷生物科技有限公司]自行提供,内容的真实性、准确性和合法性由发布会员负责。